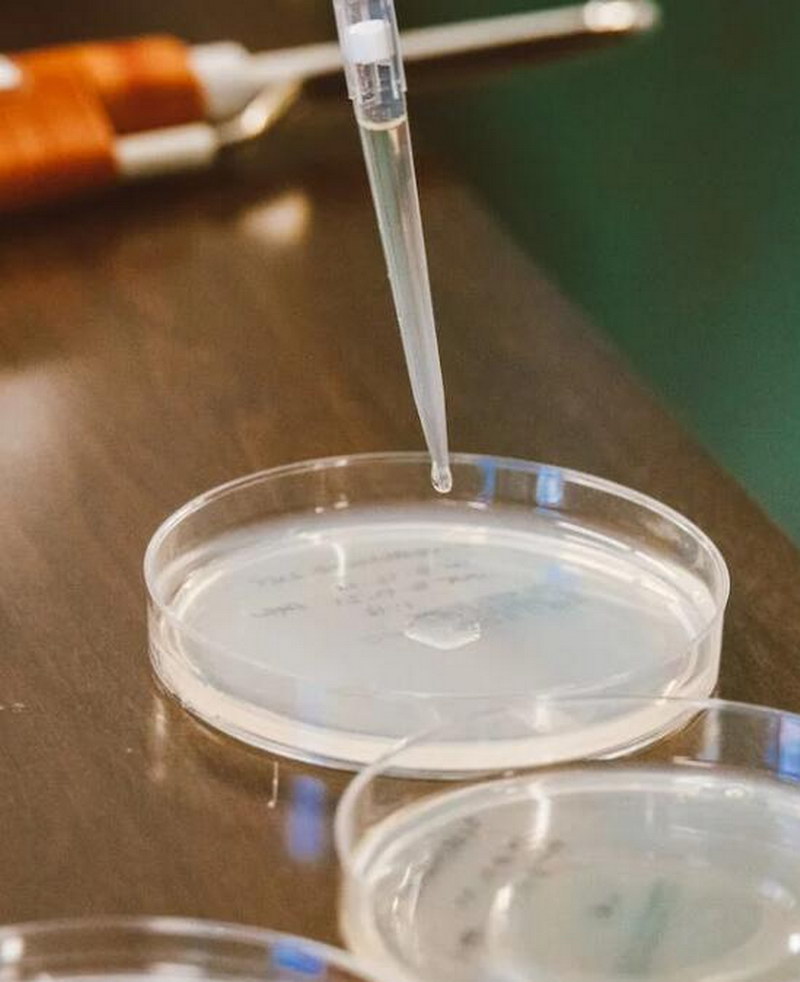
替格瑞洛杂质12

要解析杂质的结构式,通常需要使用一系列的分析方法和技术。以下是一些常用的方法:

1. 质谱(Mass Spectrometry, MS):通过将样品中的分子转化为离子,并在质谱仪中进行分析,可以得到离子的质量-电荷比。然后,通过分析质谱图中的峰位、峰形和质荷比,可以推测出杂质的分子结构。
2. 核磁共振(Nuclear Magnetic Resonance, NMR):通过测量分子中核自旋的行为,可以得到关于分子结构的信息。常用的NMR技术包括氢谱(1H-NMR)、碳谱(13C-NMR)等,可以用来分析杂质的结构。
3. 红外光谱(Infrared Spectroscopy, IR):通过测量样品对不同波长的红外辐射的吸收,可以得到样品中功能团的信息。根据红外光谱图谱和吸收峰的位置,可以推测出杂质的结构。
4. 紫外-可见光谱(Ultraviolet-Visible Spectroscopy, UV-Vis):通过测量样品对紫外-可见光的吸收情况,可以得到样品的吸收谱图。分析吸收峰的位置和强度,可以初步推测出杂质的结构。
5. 色谱分析(Chromatography):包括气相色谱(Gas Chromatography, GC)、液相色谱(Liquid Chromatography, LC)等技术。通过分离和检测杂质与其他成分的相互作用,可以帮助分析杂质的结构。
以上方法通常会结合使用,以获得更准确和全面的结果。根据分析结果,可以使用化学软件和数据库查询来推测杂质的结构,如PubChem、ChemSpider等。同时,也有专业的杂质结构解析服务和科研机构可以提供帮助。